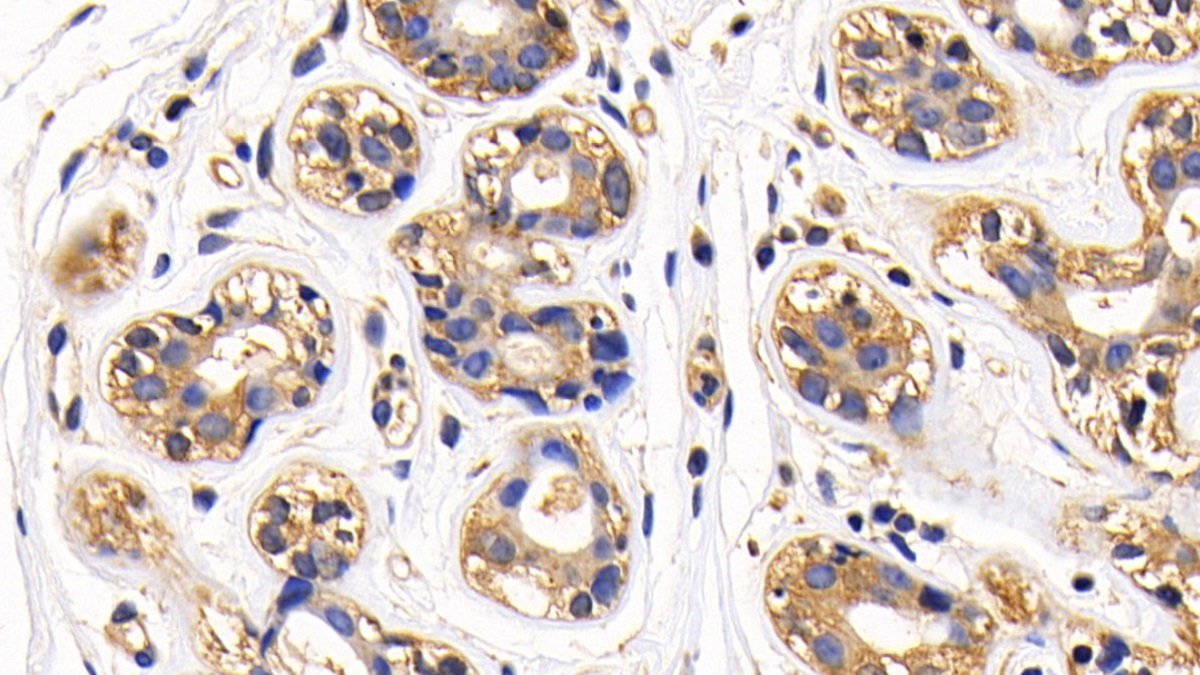
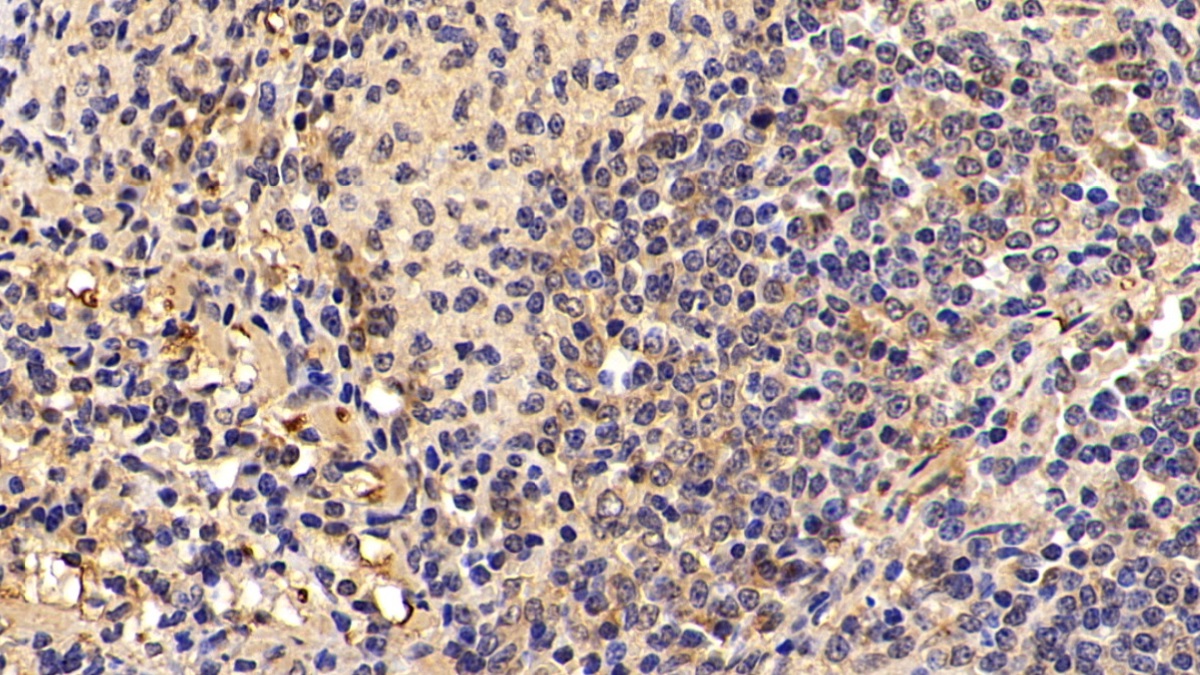

核因子κB(NFkB)多克隆抗体
Polyclonal Antibody to Nuclear Factor Kappa B (NFkB)
NF-KB1; EBP-1; KBF1; NF-Kappa-B; NFKB-P105; NFKB-P50; Nuclear Factor Of Kappa Light Polypeptide Gene Enhancer In B-Cells 1; Nuclear factor NF-kappa-B p105 subunit
- 编号PAB824Hu01
- 物种Homo sapiens (Human,人)相同的名称,不同的物种。
- 来源多抗制备
- 宿主兔
- 效价-
- Ig类型IgG
- 纯化方式抗原特异性亲和纯化
- 标记物无标记物
- 免疫原RPB824Hu01-核因子κB(NFkB)重组蛋白
- 缓冲液成份0.01M 磷酸盐缓冲液(pH7.4,containing 0.05% Proclin-300,50% glycerol)
- 性状液体
- 浓度0.5mg/mL
- 且适物种Mus musculus (Mouse,小鼠), Rattus norvegicus (Rat,大鼠), Sus scrofa; Porcine (Pig,猪), Bos taurus; Bovine (Cattle,牛)
- 应用WB; IHC; ICC/IF
如果抗体需用于流式细胞术,请参见流式抗体。 - 下载英文说明书 中文说明书
- 规格20µl100µl200µl1ml10ml
- 价格¥ 598¥ 1394¥ 1992¥ 4980¥ 19920
- 欲了解实际交易价格和更多情况,请与当地经销商联系!
特异性
该抗体是针对NFkB的兔多克隆抗体。在免疫组织化学染色和免疫印迹实验中能识别NFkB。
用法
Western blotting: 0.01-2µg/mL;
Immunohistochemistry: 5-20µg/mL;
Immunocytochemistry: 5-20µg/mL;
Optimal working dilutions must be determined by end user.
储存
经常使用则4°C保存。-20°C保存不超过两年。避免反复冻融。
稳定性
热稳定性以损失率显示。损失率是由加速降解试验决定,具体方法如下:在37°C孵育48小时,没有显著的降解或者沉淀产生。保质期内,在适当的条件下存储,损失率低于5%。
赠品
增值服务
相关产品
| 编号 | 适用物种:Homo sapiens (Human,人) | 应用(仅供研究使用,不用于临床诊断!) |
| RPB824Hu01 | 核因子κB(NFkB)重组蛋白 | Positive Control; Immunogen; SDS-PAGE; WB. |
| RPB824Hu03 | 核因子κB(NFkB)重组蛋白 | Positive Control; Immunogen; SDS-PAGE; WB. |
| RPB824Hu02 | 核因子κB(NFkB)重组蛋白 | Positive Control; Immunogen; SDS-PAGE; WB. |
| PAB824Hu01 | 核因子κB(NFkB)多克隆抗体 | WB; IHC; ICC/IF |
| PAB824Hu02 | 核因子κB(NFkB)多克隆抗体 | WB; IHC; ICC/IF |
| LAB824Hu81 | 核因子κB(NFkB)多克隆抗体(异硫氰酸荧光素标记) | WB; IHC; ICC; IF. |
| LAB824Hu71 | 核因子κB(NFkB)多克隆抗体(生物素标记) | WB; IHC; ICC. |
| MAB824Hu22 | 核因子κB(NFkB)单克隆抗体 | WB; IHC; ICC; IP. |
| SEB824Hu | 核因子κB(NFkB)检测试剂盒(酶联免疫吸附试验法) | Enzyme-linked immunosorbent assay for Antigen Detection. |
| MEB824Hu | 核因子κB(NFkB)检测试剂盒(酶联免疫吸附试验法,小样本) | Enzyme-linked immunosorbent assay for Antigen Detection. |
| LMB824Hu | 核因子κB(NFkB)等多因子检测试剂盒(流式荧光发光法) | FLIA Kit for Antigen Detection. |
| KSB824Hu01 | 核因子κB(NFkB)检测试剂盒DIY材料(酶联免疫吸附试验法) | Main materials for "Do It (ELISA Kit) Yourself". |
参考文献
| 杂志 | 参考文献 |
| Reproductice Science | Surgical Removal of Endometrioma Decreases the NF-kB1 (p50/105) and NF-kB p65 (Rel A) Expression in the Eutopic Endometrium During the Implantation Window[Sagepub: Source] |
| International Immunopharmacology | Proanthocyanidins from grape seeds modulates the nuclear factor-kappa B signal transduction pathways in rats with TNBS-induced recurrent ulcerative colitis[PubMed: 21642017] |
| PLoS One | New Method to Isolate and Culture Rat Kupffer Cells[PubMed: PMC3743898] |
| World Journal of Gastroenterology | Long-term aspirin pretreatment in the prevention of cerulein-induced acute pancreatitis in rats[PubMed: PMC3660814] |
| Experimental and Therapeutic Medicine | Shuangtengbitong tincture treatment of collagen-induced arthritis via downregulation of the expression of IL-6, IL-8, TNF-α and NF-κB[PubMed: PMC3570159] |
| PLoS One. | Cilostazol Renoprotective Effect: Modulation of PPAR-γ, NGAL, KIM-1 and IL-18 Underlies Its Novel Effect in a Model of Ischemia-Reperfusion[Pubmed:24816434] |
| Free Radical Biology and Medicine | Involvement of nitric oxide with activation of Toll-like receptor 4 signaling in mice with dextran sodium sulfate-induced colitis[Pubmed:24992835] |
| BBA Clin | Long-term warfarin therapy and biomarkers for osteoporosis and atherosclerosis[PubMed: 26674156] |
| J Clin Diagn Res | Serological Analysis of Alpha-synuclein and NF-κB in Parkinson’s Disease Patients[PubMed: 26155470] |
| Eur J Obstet Gynecol Reprod Biol | Hysteroscopic polypectomy decreases NF-κB1 expression in the mid-secretory endometrium of women with endometrial polyp[PubMed: 25898371] |
| Asian Pacific Journal of Cancer Prevention | Plasma nuclear factor kappa B and serum peroxiredoxin 3 in early diagnosis of hepatocellular carcinoma.[PubMed: 25743848] |
| Acta Biochim Pol | Preventive use of Lactobacillus plantarum LS/07 and inulin to relieve symptoms of acute colitis.[PubMed: 26345092] |
| Acta Veterinaria | Use Of The Prebiotic Inulin In The Prevention Of Adverse Signs Of Acute Colitis[View: J] |
| Neurochem Res | Protective Effect of Oral Hesperetin Against Unilateral Striatal 6-Hydroxydopamine Damage in the Rat[PubMed: 26700436] |
| Transplant Proc | L-Alanyl-Glutamine Attenuates Oxidative Stress in Liver Transplantation Patients[PubMed: 26518955] |
| Journal of Food Science | Effects of Hyriopsis cumingii Polysaccharides on Mice Immunologic Receptor, Transcription Factor, and Cytokine[Pubmed:27061742] |
| IJBPAS | THE PROPHYLACTIC EFFICIENCY OF LYCOPENE AGAINST GAMMA IRRADAITION-INDIUCED CARDIAC OXIDATIVE DAMAGE, PATHOLOGY AND APOPTOSIS IN RATS[publication:298838934] |
| Basic & Clinical Pharmacology & Toxicology | Placental Growth Factor Triggers Epithelial-to-Mesenchymal Transition-like Changes in Rat Type II Alveolar Epithelial Cells: Activation of Nuclear Factor κB Signalling Pathway[doi:10.1111] |
| Peptides. | Carnosine ameliorates cognitive deficits in streptozotocin-induced diabetic rats: Possible involved mechanisms.[pubmed:27777064] |
| british journal of pharmacology | Forskolin, a hedgehog signalling inhibitor, attenuates carbon tetrachloride-induced liver fibrosis in rats.[pubmed:27590029] |
| european journal of pharmacology | Garlic active constituent s-allyl cysteine protects against lipopolysaccharide-induced cognitive deficits in the rat: Possible involved mechanisms.[pubmed:27915041] |
| european journal of pharmacology | S-allyl cysteine ameliorates cognitive deficits in streptozotocin-diabetic rats via suppression of oxidative stress, inflammation, and acetylcholinesterase.[pubmed:27887948] |
| Psychopharmacology (Berl) | Ellagic acid ameliorates learning and memory deficits in a rat model of Alzheimer's disease: an exploration of underlying mechanisms.[pubmed:28303372] |
| biomedicine & pharmacotherapy | Acetyl-l-carnitine protects dopaminergic nigrostriatal pathway in 6-hydroxydopamine-induced model of Parkinson's disease in the rat.[pubmed:28199883] |
| biomedicine & pharmacotherapy | Diosgenin ameliorates development of neuropathic pain in diabetic rats: Involvement of oxidative stress and inflammation.[pubmed:28033582] |
| Toxicology and Applied Pharmacology | Sildenafil protects against bile duct ligation induced hepaticfibrosis in rats: Potential role for silent information regulator 1 (SIRT1)[pubmed:28974454] |
| Microbial Immunology | Immunomodulatory Activities of a Fungal Protein Extracted from Hericium erinaceus through Regulating the Gut Microbiota[pubmed:28713364] |
| Journal of Biomechanics | The shear wave elastic modulus and the increased nuclear factor kappa B(NF-kB/p65) and cyclooxygenase-2 (COX-2) expression in the area of myofascial trigger points activated in a rat model by blunt trauma to the vastus medialis[pubmed:29137729] |
| European Journal of Pharmacology | In vivo cellular and molecular gastroprotective mechanisms of chrysin; Emphasis on oxidative stress, inflammation and angiogenesis[pubmed:29126792] |
| Frontiers in Pharmacology | Docking Studies and Biological Evaluation of a Potential β-Secretase Inhibitor of 3-Hydroxyhericenone F from Hericium erinaceus.[pubmed:28553224] |
| International Journal of Medicinal Mushrooms | Anti-Inflammatory Activity and Bioactive Constituents of Cultivated Fruiting Bodies of Xylaria nigripes (Ascomycetes), a Chinese Medicinal Fungus.[pubmed:29256845] |
| Biomedicine & pharmacotherapy | Berberine ameliorates intrahippocampal kainate-induced status epilepticus and consequent epileptogenic process in the rat: Underlying mechanisms[pubmed:28061403] |
| International Immunopharmacology | Scutellarin alleviates lipopolysaccharide-induced cognitive deficits in the rat: Insights into underlying mechanisms.[pubmed:29190543] |
| Food and Chemical Toxicology | Antioxidant, anti-inflammatory and synergistic anti-hyperglycemic effects of Malaysian propolis and metformin in streptozotocin–induced diabetic rats[Pubmed:30026088] |
| Neurotoxicity Research | Protective Effects of Fibroblast Growth Factor 21 Against Amyloid-Beta-Induced Toxicity in SH-SY5Y Cells[Pubmed:29869772] |
| European Journal of Pharmacology | Naringenin ameliorates learning and memory impairment following systemic lipopolysaccharide challenge in the rat[Pubmed:29518393] |
| Experimental biology and medicine (Maywood) | Shock waves increase pulmonary vascular leakage, inflammation, oxidative stress, and apoptosis in a mouse model[Pubmed:29984607] |
| Acta Veterinaria Belgrade | Anti-inflammatory potential of Lactobacillus plantarum LS/07 in acute colitis in rats[10.2478:acve-2018-0005] |
| Taiwanese Journal of Obstetrics & Gynecology | HMGB1-RAGE signaling pathway in pPROM[Pubmed:29673663] |
| Acta Veterinaria Brno | Improvement of colitis by LS/07 and inulin[10.2754:avb201786040399] |
| Drug Discoveries & Therapeutics | The potential antifibrotic impact of apocynin and alpha-lipoic acid in concanavalin A-induced liver fibrosis in rats: Role of NADPH oxidases 1 and 4[Pubmed:29760339] |
| Life Sciences | Malaysian propolis, metformin and their combination, exert hepatoprotective effect in streptozotocin-induced diabetic rats[Pubmed: 30205096] |
| Life Sciences | Sitagliptin attenuates intestinal ischemia/reperfusion injury via cAMP/PKA, PI3K/Akt pathway in a glucagon-like peptide 1 receptor-dependent manner[Pubmed: 30195035] |
| Journal of Traditional Chinese Medical Sciences | Effect of Dachaihu Decoction on non-alcoholic fatty liver disease model rats induced by a high-fat high-sugar diet[] |
| Naunyn-Schmiedeberg's archives of pharmacology | Amitriptyline attenuates bleomycin-induced pulmonary fibrosis: modulation of the expression of NF-κβ, iNOS, and Nrf2[Pubmed: 30474696] |
| Archives of Physiology and Biochemistry | Diabetes-induced testicular oxidative stress, inflammation, and caspase-dependent apoptosis: the protective role of metformin[Pubmed: 30513216] |
| Journal of Functional Foods | Complex interaction of dietary fat and Alaskan bog blueberry supplementation influences manganese mediated neurotoxicity and behavioral impairments[] |
| Scientific Reports | Anti-breast Cancer Activity of SPG-56 from Sweet Potato in MCF-7 Bearing Mice in Situ through Promoting Apoptosis and Inhibiting Metastasis[Pubmed: 30651572] |
| Journal of Pain Researc | Increased cerebral nuclear factor kappa B in a complex regional pain syndrome rat model: possible relationship between peripheral injury and the brain[Pubmed: 30881100] |
| Antioxidants | Oxidative Stress, NF-κB-Mediated Inflammation and Apoptosis in the Testes of Streptozotocin–Induced Diabetic Rats: Combined Protective Effects of Malaysian …[Pubmed: 31600920] |
| journal of biochemical and molecular toxicology | Indomethacin and juglone inhibit inflammatory molecules to induce apoptosis in colon cancer cells[Pubmed: 31916655] |
| Life Sci | New insights into the protection of growth hormone in cisplatin-induced nephrotoxicity: The impact of IGF-1 on the Keap1-Nrf2/HO-1 signaling[Pubmed: 32209424] |
| European Review for Medical and Pharmacological Sciences | Effects of lncRNA gm4419 on rats with hypertensive cerebral atherosclerosis through NF-κB pathway[Pubmed: 31858567] |
| J Ethnopharmacol | Effects of fermented ginseng on the gut microbiota and immunity of rats with antibiotic-associated diarrhea[Pubmed: 33217518] |
| Odontology | Effects of different pulp-capping materials on cell death signaling pathways of lipoteichoic acid-stimulated human dental pulp stem cells[Pubmed: 33206337] |
| LIFE SCIENCES | Effects of combined treatment with Indomethacin and Juglone on AOM/DSS induced colon carcinogenesis in Balb/c mice: Roles of inflammation and …[Pubmed: 33148421] |
| JOURNAL OF ETHNOPHARMACOLOGY | Morroniside attenuates apoptosis and pyroptosis of chondrocytes and ameliorates osteoarthritic development by inhibiting NF-κB signaling[Pubmed: 33022338] |
| Journal of Cosmetic Dermatology | Examination of androgenetic alopecia with serum biomarkers[Pubmed: 32969583] |
| NEUROPSYCHOBIOLOGY | Diosgenin Attenuates Cognitive Impairment in Streptozotocin-Induced Diabetic Rats: Underlying Mechanisms[Pubmed: 32526752] |
| journal of ethnopharmacology | UPLC-Orbitrap HRMS metabolic profiling of Cymbopogon citratus cultivated in Egypt; neuroprotective effect against AlCl3-induced neurotoxicity in rats[Pubmed: 32376365] |
| BIOMEDICINE & PHARMACOTHERAPY | Protective effects of bee bread on testicular oxidative stress, NF-κB-mediated inflammation, apoptosis and lactate transport decline in obese male rats[Pubmed: 33152939] |
| Journal of Diabetes Research | Regulation and Mechanism of miR-518d through the PPARα-Mediated NF-κB Pathway in the Development of Gestational Diabetes Mellitus[Pubmed: 33123597] |
| Folia Biologica | Effect of Graviola (Annona Muricata l.) and Ginger (Zingiber Officinale Roscoe) on Diabetes Mellitus Induced in Male Wistar Albino Rats[] |
| TOXICOLOGY IN VITRO | Cyproheptadine causes apoptosis and decreases inflammation by disrupting thiol/disulfide balance and enhancing the levels of SIRT1 in C6 glioblastoma cells[33675893] |
| Hum Exp Toxicol | Alamandine significantly reduces doxorubicin-induced cardiotoxicity in rats[33882726] |
| J Food Biochem | Masseter muscle and gingival tissue inflammatory response following treatment with high©\fructose corn syrup in rats: Anti©\inflammatory and antioxidant effects of kefir[33864286] |
| Open Access Macedonian Journal of Medical Sciences | The Potential of Nano Curcumin in Preventing the Formation of Artificial Antisperm Antibody in Wistar Rats through Inflammatory Pathway Regulation[] |
| Eur Rev Med Pharmacol Sci | Vitamin D supplementation inhibits NF-kß signaling pathway in lean and obese women with PCOS[Pubmed:35731068] |
| BMC Nephrol | Effect of subacute poisoning with lambdacyhalothrin on vascular endothelial growth factor 2 receptor in mice kidneys[Pubmed:35643467] |
| Antioxidants | Therapeutic Effects of Bee Bread on Obesity-Induced Testicular-Derived Oxidative Stress, Inflammation, and Apoptosis in High-Fat Diet Obese Rat Model …[Pubmed:35204140] |
| Journal of Pharmaceutical Research International | Concomitant Administration of Rosuvastatin and Lefleunamide in Low doses Synergize Against Complete Freund's Adjuvant (CFA)-Induced Rheumatoid …[] |